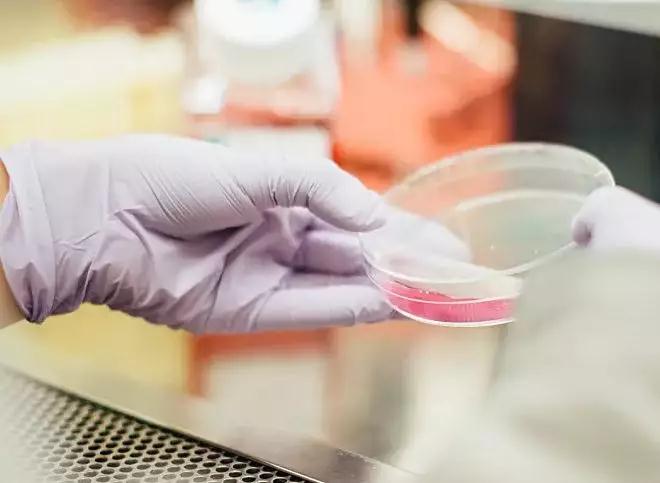

十字花科蔬菜堪称饮食领域的“防癌扛把子”,多项研究都证实了这类蔬菜的抗癌和抑癌作用。
近期的一项研究证明十字花科蔬菜含有的吲哚类物质,可能影响肿瘤细胞的生长,甚至有治疗作用。而另一项研究则直接证实了它能降低乳腺癌发病风险。
防癌,抗癌,十字花科蔬菜究竟有何与众不同?
膳食纤维被夸错了!吲哚才是功臣
以往的研究者认为,十字花科蔬菜防癌的功效主要是因为含有大量膳食纤维,不过最新的一项研究显示,十字花科防癌的作用可能是另外一种物质在起效,膳食纤维很有可能冒领了别人的功劳!

这项来自伦敦弗朗西斯・克里克研究所发表在《细胞》子刊《免疫》杂志上,研究者们发现,十字花科蔬菜所含有的吲哚类物质,可能才是具有防癌功效的幕后功臣。
说到吲哚类物质,大家可能不太熟悉,不过很多化学专业的人都说吲哚的气味就和粪便一样。这并不是空穴来风,因为有一类吲哚就是“粪臭素3-甲基吲哚”。除此之外,生活中的吲哚物质还有人体必需的色氨酸、植物生长素吲哚乙酸等等。
但是这项研究提到的吲哚类物质,主要指蔬菜中的吲哚-3-甲醇,大部分存在于十字花科蔬菜中。人们在咀嚼蔬菜的过程中,吲哚-3-甲醇在胃酸和肠道菌群的作用下,会产生一种激活芳羟受体的物质。这种化学物质可促进肠道内膜和控制发炎的免疫细胞的再生。
芳羟受体和肿瘤的发生到底有没有关系呢?
研究人员给三种小鼠注射了诱变剂,这三种小鼠,第一种小鼠体内敲除了芳羟受体,第二种小鼠体内含有耗尽芳羟受体的配体的过表达CYP1A1酶,第三种是正常的小鼠。4个月后,前两种小鼠体内都出现了大量的肿瘤细胞,正常小鼠体内并没有出现肿瘤细胞。

但是如果在注射诱变剂前两周,喂养三种小鼠时添加吲哚-3-甲醇,第二种小鼠肿瘤细胞就会大大地减少,正常的小鼠的肿瘤发生率竟然降低为0。
这样看来,激活芳羟受体可以预防肿瘤的发生。那对于已经发生的肿瘤有没有效果呢?
研究人员在体内含CYP1A1过表达的小鼠中和正常小鼠的食物中,继续添加吲哚-3-甲醇。观察了6个星期之后发现,没有喂养吲哚-3-甲醇的小鼠都长了肿瘤,有喂养吲哚-3-甲醇的小鼠的肿瘤数量比正常小鼠要少。
这样看来,激活芳羟受体还有治疗肿瘤的效果呢。
本研究的通讯作者Stockinger说,“尽管我们不能改变增加我们患癌症风险的基因因素,但我们可以通过采取适当的饮食和大量的蔬菜来减轻这些风险。”
可降低11%的乳腺癌风险
2018年7月6日,国际抗癌联盟官方期刊《国际癌症杂志》发表一则记录10911例乳腺癌患者的研究报告,报告结果显示:每增加摄入2份/天的水果蔬菜(尤其是十字花科和黄橙色蔬菜),乳腺癌风险显著减少11%。其中包括HER2阳性激素受体阴性乳腺癌和三阴乳腺癌。
小贴士:
一份蔬菜等于500g西红柿、黄瓜
或400g白萝卜、茭白、青椒
或300g鲜豇豆、豆角
或250g扁豆、洋葱、蒜苗
或200g胡萝卜、山药、荸荠
美国癌症研究学会《癌症预防研究》的研究也报告过,十字花科蔬菜中含有一种名为异硫氰酸的抗氧化物,并针对异硫氰酸对癌细胞的作用做了一个实验。
研究人员以45名乳腺癌患者为对象,让部分研究对象服用安慰剂,剩下的研究对象服用含有一定剂量的异硫氰酸增补剂。结果显示,服用过异硫氰酸增补剂的乳腺癌患者细胞生长指数下降,有效减缓癌细胞的生长。
如此看来,乳腺癌患者摄取十字花科蔬菜好处多多,那么关于十字花科蔬菜都有哪些,要怎么吃,你又了解多少呢?
十字花科蔬菜都有啥?
十字花科家族数量庞大,几乎占据了人类食用蔬菜的半壁江山,以下列举几种常见的十字花科蔬菜。

另外,十字花科蔬菜在烹煮时要注意以下几点:
1.洗的时候不需要浸泡太久,以免细胞损伤,切好后马上开始烹调。
2.烹调加热至断生立马出锅,可以保持蔬菜的嫩脆感,也能保留更多的异硫氰酸。
3.十字花科含异硫氰酸,因此带有一股辣味,可以尝试炒、炖的方式,可以改善口感。
4.如果担心农药残留,可快速在沸水中焯一下再进行下一步烹饪。

了解了十字花科蔬菜的抗癌功效,很多患者朋友可能会增加日常的食用量了,甚至会只想吃它们。千万不要这样,只吃一种食物的防癌抗癌效果是微乎其微的,建议大家还是合理搭配饮食哦!